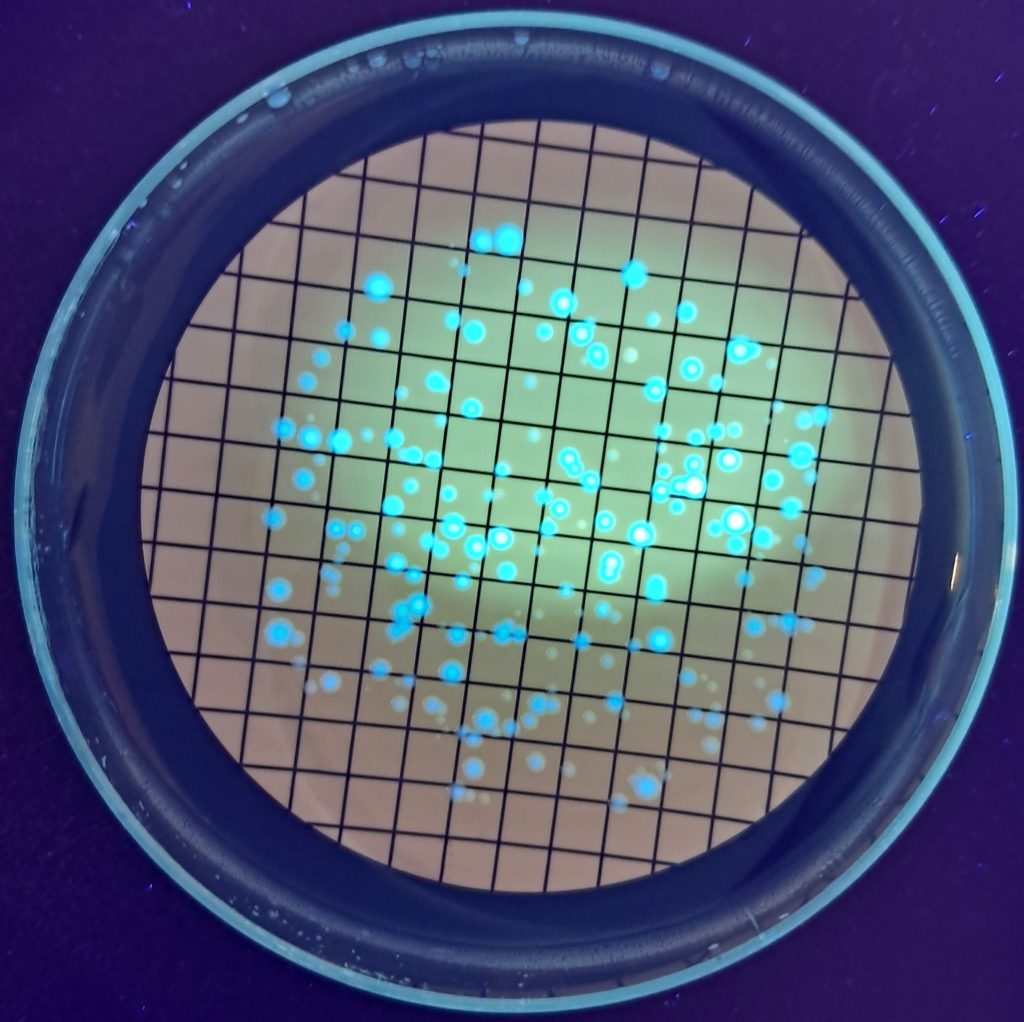

En LABORATORIO GEA realizamos análisis de legionella por Cultivo (Según la Norma ISO 17025)
Nuestra empresa se encuentra actualmente acreditada por ENAC para realizar dicho análisis, el Real Decreto 487/2022 por el que se describen los criterios higiénico-sanitarios para la prevención y control de la legionelosis exige que el análisis de Legionella se realice según dicha norma ISO 11731.
LABORATORIO GEA está acreditado para el análisis de legionella, con número de certificado nº5188_LE_2879